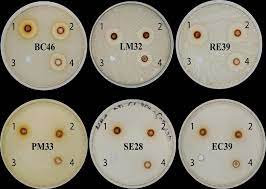

Bài báo KH&CN
Chính sách khuyến khích sáng tạo và ứng dụng công nghệ mới vùng Tây Nguyên trong bối cảnh mới
Ngày:13/11/2023
Bài viết là sản phẩm của đề tài cấp Quốc gia "Giải pháp chính sách khuyến khích sáng tạo...
Phân lập và tuyển chọn một số vi sinh vật từ phân voi ứng dụng trong xử lí vỏ cây nha đam tạo thành phân compost
Ngày:13/11/2023
Tại Việt Nam, voi thường được tìm thấy ở khu vực Tây Nguyên, đặc biệt là Đắk Lắk. Voi tiều thụ lên đến 300 kg thức ăn...
Một số đặc điểm hạn thủy văn ở khu vực Tây Nguyên trong giai đoạn 1980–2015
Ngày:13/11/2023
Chỉ số dòng chảy chuẩn hóa SSI được sử dụng để phân tích một số đặc điểm hạn thủy văn tại 8 trạm ở khu vực Tây...
Kết quả chọn tạo giống vừng BĐ.01 cho vùng Duyên Hải Nam Trung Bộ và Tây Nguyên
Ngày:13/11/2023
Giống vừng BĐ.01 được chọn lọc từ tổ hợp lai CUMS-17 × vừng vàng Bình Định. Giống có dạng thân đứng, thuộc kiểu...
Sinh trưởng và sản lượng hạt của các dòng Mắc ca ở giai đoạn sau 10 năm tuổi tại Tây Nguyên
Ngày:13/11/2023
Mục tiêu của nghiên cứu nhằm đánh giá và chọn lọc các dòng Mắc ca có năng suất hạt cao ở giai...
Ảnh hưởng của phương pháp che phủ đất trong canh tác mía trên Đất Dốc Tây Nguyên
Ngày:13/11/2023
Khảo nghiệm các phương pháp che phủ đất trong canh tác mía được tiến hành trên đất dốc tại xã Ea Sar,...
Thu thập và phân lập các chủng nấm đạo ôn Magnaporthe oryzae hại lúa ở miền Bắc và miền Trung Việt Nam
Ngày:13/11/2023
Bệnh đạo ôn lúa (Magnaporthe oryzae) gây ra những thiệt hại nghiêm trọng cho sản xuất lúa trên thế giới...
Chọn tạo giống đậu xanh ĐXBĐ.08 cho vùng Duyên Hải Nam Trung Bộ và Tây Nguyên
Ngày:13/11/2023
Nghiên cứu được thực hiện từ năm 2015 đến 2022 nhằm chọn tạo giống đậu xanh mới ngắn ngày, chín tập trung, năng suất cao và...
Một số kết quả đạt được trong xây dựng mô hình OCOP (One Commune One Product - Mỗi xã một sản phẩm) dựa vào nội lực cộng đồng tại tỉnh Đắk Lắk
Ngày:13/11/2023
Sau 12 tháng triển khai nghiên cứu, đề tài đã hệ thống hóa cơ sở lý luận và thực tiễn xây dựng...
Yếu tố nền tảng kinh tế và các kết nối cứng để phát triển công nghiệp chế biến tỉnh Đắk Lắk
Ngày:13/11/2023
Dựa trên các số liệu thứ cấp thu thập được, bài viết này tập trung (i) nghiên cứu các yếu tố nền tảng kinh tế...
Hiệu quả chăn nuôi bò thịt theo loại hình khác nhau ở Tây Nguyên
Ngày:13/11/2023
Mục tiêu của nghiên cứu này là xác định và tìm ra phương thức chăn nuôi bò thịt phù...
Thực trạng thoái hóa đất và quản lý, xác định diện tích đất bị thoái hóa ở Việt Nam
Ngày:13/11/2023
Trong giai đoạn 2015 - 2020, Bộ Tài nguyên và Môi trường đã tổng điều tra, đánh giá tài...
Nâng cao năng lực cạnh tranh hồ tiêu xuất khẩu ở các tỉnh Tây Nguyên - Những vấn đề đặt ra
Ngày:13/11/2023
Hồ tiêu là cây công nghiệp dài ngày, có giá trị kinh tế cao và được trồng ở hầu hết ở...
Khảo sát khả năng ức chế của cao chiết ethanol hạt xay nhung trên một số chủng vi khuẩn gây bệnh
Ngày:13/11/2023
Nhiễm khuẩn là một trong những vấn đề lớn lên sức khoẻ của con người, bên cạnh đó tình trạng kháng...
Ảnh hưởng của tỷ lệ nguồn gen bò Droughtmaster đến khả năng sinh trưởng của con lai tại Tây Nguyên
Ngày:13/11/2023
Mục tiêu chính là đánh giá khối lượng cơ thể, mức tăng khối lượng cơ thể trung bình hàng ngày,...
Ảnh hưởng của loại phân, lượng phân và số lần bón phân cho mía trên đất dốc Tây Nguyên
Ngày:13/11/2023
Khảo nghiệm các loại phân, lượng phân và số lần bón phân nhằm mục đích tìm ra loại phân,...
Ảnh hưởng của hai chủng vi khuẩn vùng rễ Stenotrophomonas maltophilia RDL1B41 và Enterobacter mori RDL3B74 đến sinh trưởng, phát triển và năng suất của cây lúa tím trong điều kiện nhà màng
Ngày:13/11/2023
Hai chủng vi khuẩn Stenotrophomonas maltophilia RDL1B41 và Enterobacter mori RDL3B74 được phân lập từ đất vùng rễ cây...
Tích hợp tư liệu viễn thám và GIS trong theo dõi biến động sử dụng đất tại huyện Ea Súp, tỉnh Đắk Lắk
Ngày:13/11/2023
Biến động sử dụng đất và sự thay đổi lớp phủ thực vật là vấn đề quan trọng trong một loạt các vấn đề nghiên cứu về biến đổi...
Ảnh hưởng của Bacilllus amyloliquefaciens EK2 đến sinh trưởng của cây bạc hà (Mentha arvensis L.) trong điều kiện nuôi cấy in vitro và ex vitro
Ngày:13/11/2023
Định danh; Lan gấm; Phân bốCây Bạc hà {Mentha arvensis L.) được xem là nguồn dược liệu quý, tiềm năng nhằm...
Xác định dư lượng carbamate trong bắp cải tại Thành phố Buôn Ma Thuột, tỉnh Đắk Lắk
Ngày:10/11/2023
Dư lượng thuốc bảo vệ thực vật trong cây trồng có thể ảnh hưởng đến sức khỏe con người do độc tính của chúng hoặc bị...